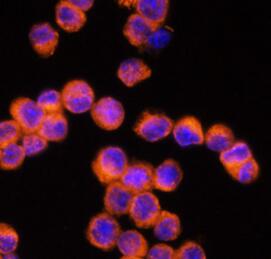
NLRP3 antibody|NLRP3抗体 FNab101

相关产品推荐更多 >
万千商家帮你免费找货
0 人在求购买到急需产品
- 详细信息
- 询价记录
- 文献和实验
- 技术资料
- 免疫原:
NLR family, pyrin domain containing 3
- 亚型:
IgG
- 形态:
liquid
- 保存条件:
-20℃ 12月
- 克隆性:
polyclonal
- 标记物:
未标记
- 适应物种:
Human, Mouse, Rat
- 保质期:
-20℃ 12月
- 抗原来源:
NLR family, pyrin domain containing 3
- 目录编号:
FNab10120
- 级别:
科研
- 库存:
100
- 供应商:
武汉菲恩生物科技有限公司
- 宿主:
Rabbit
- 应用范围:
ELISA, WB, IHC, IF
- 靶点:
NLRP3
- 抗体英文名:
NLRP3 antibody
- 抗体名:
NLRP3抗体
- 规格:
50ug/100ug
| 规格: | 50ug | 产品价格: | ¥1140.0 |
|---|---|---|---|
| 规格: | 100ug | 产品价格: | ¥1900.0 |

产品介绍
| 产品名称 | NLRP3 antibody |
| 中文名称 | NLRP3抗体 |
| 货号 | FNab10120 |
| 规格 | 50ug/100ug |
| 宿主 | Rabbit |
| 反应种属 | Human, Mouse, Rat |
| 验证应用 | ELISA, WB, IHC, IF |
| 状态 | liquid |
| 纯化方法 | Immunogen affinity purified |
| 纯度 | ≥95% as determined by SDS-PAGE |
| 克隆性 | polyclonal |
| 亚型 | IgG |
| 免疫原 | NLR family, pyrin domain containing 3 |
| 免疫原别称 | NACHT, LRR and PYD domains-containing protein 3|Angiotensin/vasopressin receptor AII/AVP-like|Caterpiller protein 1.1 (CLR1.1)|Cold-induced autoinflammatory syndrome 1 protein|Cryopyrin|PYRIN-containing APAF1-like protein 1|NLRP3|C1orf7|CIAS1|NALP3|PYPAF1 |
| Uniprot ID | Q96P20 |
| 分子量 | 118 kDa |
| 建议稀释比例 | WB: 1:200-1:2000; IHC: 1:50-1:200; IF: 1:50-1:200 |
| 验证图片 |  Immunohistochemistry of paraffin-embedded rat lung using FNab10120 (NLRP3 antibody) at dilution of 1:100 Immunofluorescence analysis of Raw264.7 cells using FNab10120 (NLRP3 antibody) at dilution of 1:100  mouse brain tissue were subjected to SDS PAGE followed by western blot with FNab10120 (NLRP3 antibody) at dilution of 1:1000 |
| 存储 | PBS with 0.02% sodium azide and 50% glycerol pH 7.3, -20℃ for 12 months(Avoid repeated freeze / thaw cycles.) |
| 注意事项 | NLRP3 antibody仅供科研使用 |
菲恩生物抗体产品优势
种类齐全:有10000多种经过验证的免多抗和小鼠单抗,包括流式抗体、内参抗体、标签抗体、小分子化合物抗体、对照抗体等;
多种标记/非标记二抗:针对兔、羊、小鼠、大鼠、人等多个种属。100多种标记二抗,标记物包括HRP、Biotin、FITC、Cy3、Alexa Fluor 488、Alexa Fluor 594等,通过了蛋白质印迹、免疫荧光、免疫组织化学、流式细胞术和ELISA等免疫学相关应用的充分验证,可满足各种实验需求;
验证过多种实验:ELISA、WB、IHC、IF、IP、FC等应用,并进行了广泛的物种交叉实验。
风险提示:丁香通仅作为第三方平台,为商家信息发布提供平台空间。用户咨询产品时请注意保护个人信息及财产安全,合理判断,谨慎选购商品,商家和用户对交易行为负责。对于医疗器械类产品,请先查证核实企业经营资质和医疗器械产品注册证情况。
- 作者
- 内容
- 询问日期
 文献和实验
文献和实验「铲屎官」注意了!剑桥大学揭示这些基因的改变或让猫猫狗狗成为
引起的细胞裂解及 IL-1β 的激活,说明 NLRP3 在肉食动物中活性降低。基于上述研究结果,研究者进一步探究了其他影响肉食动物炎症小体反应性的因素。利用 CRISPR-Cas9 技术敲除 caspase-8 蛋白,发现其能够显著影响犬的巨噬样细胞对于鼠伤寒沙门菌的反应性。图片来源:Cell Reports炎症小体激活促进消皮素 D 蛋白孔道的形成对于肉食动物,炎症小体的刺激因素虽然使消皮素 D 被激活从而形成孔道,但在一定程度上损伤了细胞裂解死亡途径。由于缺乏直接观察消皮素 D 的抗体,研究
JCI 重磅:王福生院士团队发现 HIV 感染者体内 T 细胞损耗元凶!
仍然是领域内尚未解决的科学问题。 2021 年 3 月 15 日,中国人民解放军总医院第五医学中心感染性疾病科 & 国家传染病临床研究中心王福生院士团队在 JCI 发表了题为 NLRP3 inflammasome induces CD4+ T cell loss in chronically HIV-1–infected patients 的研究性论文,该研究揭示了 NLRP3 依赖的细胞焦亡在 HIV-1 感染患者的 CD4+ T 细胞损耗中扮演着重要角色,并提示细胞焦亡信号可作为 HIV
流式细胞术应用 | 鉴别 NLRP3 敲除小鼠的循环髓系细胞群
实验简介表面标志物通常用于区分循环血液中的群体。使用表面标志物 Ly6C(造血细胞)、Ly6 G(粒细胞 / 嗜中性粒细胞)和 CD115(MCSF 受体),我们能够描述来自 C57BL/6J 野生型对照小鼠和 NLRP3 敲除样品的新鲜血液中的 循环细胞群。由于 NLRP3 可影响炎症小体形成,所以我们假设单核细胞与粒细胞比例会有差异。此外,我们有兴趣观察对照组与基因敲除组之间 CD115(MCSF 受体)的表达。CytoFLEX 流式细胞仪对于探寻血液循环中的不同亚群具有优良的性能。专有
 技术资料
技术资料暂无技术资料 索取技术资料








